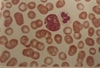

PRAKTYK Krew Flashcards
1
Q

A
Rozmaz krwi ludzkiej,
Metoda May-Grunwald-Giemza
- Bezjądrzaste erytrocyty – ludzka,
- Limfocyt (największe jądro, bardzo mało cytoplazmy, jądro zajmuje
- prawie całą prsestrzeń,),
- Monocyt (nerkowate jądro, duże),
- Neutrofile (wyraźnie segmentowate jądro, najczęściej trójdzielne),
- Eozynofile (czerwona cytoplazma (jak erytrocyty) i 2-3 dzielne jądro),
- Płytki krwi (małe komórki obecne pomiędzy innymi),
2
Q

A
- trzy różne typy komórek leukocytów
- duża kom. pełna drobnych ziarnistości to granulocyt zasadochłonny
- obok granulocyt obojętnochłonny
- na dole limfocyt - wielkość porównywalna do erytrocytów, stosunek wielkości jądra do cytoplazmy
3
Q

A
- między erytrocytami widać płytki krwi - trombocyty, nie widać w nich żadnych struktur
- granulocyt obojętnochłonny - ma drobne ziarna zawierające różnorodne substancje biorące udział w procesach obronnych
4
Q
A
- po lewej granulocyt kwasochłonny, zwykle jego jądro ma dwa segmenty, wyraźne ziarna; ziarna wyraźnie większe niż ziarna neutrofili; zawierają mediatory, enzymy
- po prawej neutrofil,
5
Q

A
- granulocyt obojętnochłonny
- ma silnie segmentowane jądro
- rakietkowata wypustka na górnym biegunie jądra - pałeczka dobosza; wystepuje u płci żeńskiej i odpowiada ciałku Barra
6
Q

A
- limfocyty
- wyróżnia je wyraźny stosunek wielkości jądra do reszty cytoplazmy
- delikatne ziarnistości azurochłonne, niewidoczne zwykle w zwykłym barwieniu
- nie da się w zwykłym rozmazie odróżnić limfocytów B od T
7
Q

A
- monocyt
- ma zawsze duże i wgłębione jądro, nigdy okrągłe jak w limfocytach
- często mozna zaobserwować delikatne azurochłonne ziarnistości